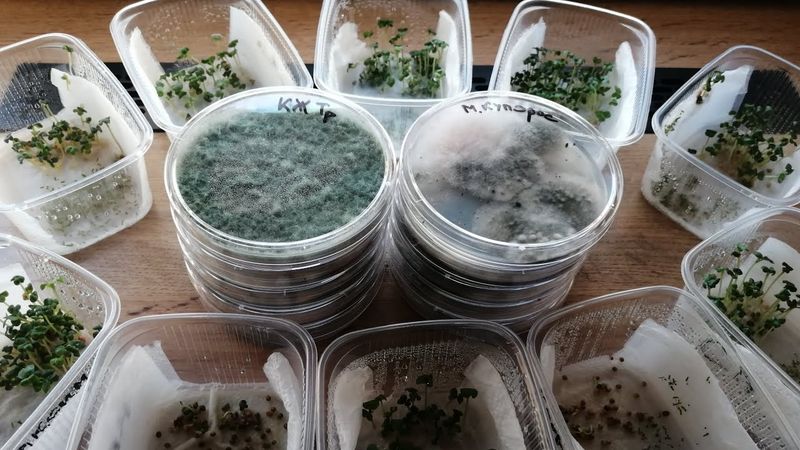
Чем протравить семена перед посевом?

Чем протравить семена перед посевом?
Download-Informationen und Videodetails Чем протравить семена перед посевом?
Autor:
]|[ Био РИНГ ]|[Veröffentlicht am:
23.3.2025Aufrufe:
2.1KÄhnliche Videos: Чем протравить семена перед посевом

НЕОГРАНИЧЕННЫЙ ЗАПАС МЕТАРИЗИУМА. Как в домашних условиях наращивать самостоятельно метаризиум.

Как выучить Таро за неделю? Самая главная ошибка новичков!

Перший зібраний урожай на Львівщині | Нашестя сарани | Що вирощувати новим фермерам?| Тетяна Борушок

Как связать крючком лошадку – символ 2026 года | МК по вязанию игрушки-подушки для новичков.

КАК НАЧИНАТЬ СВОЙ ДЕНЬ ХРИСТИАНИНУ ? Протоиерей Димитрий Беженарь

